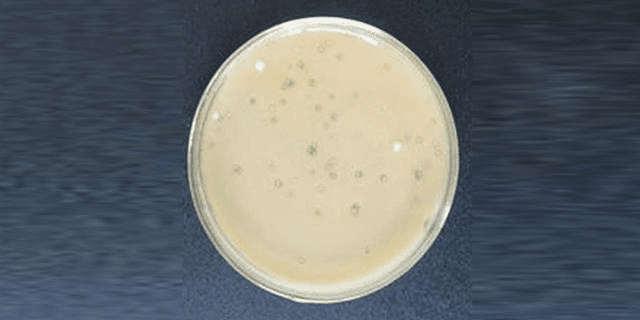

- 歡迎來到廣東(dōng)天峰消泡劑有限公司官方網站!
- 在線客服QQ 網站地圖 免(miǎn)費拿樣
-
 專研(yán)高品質
專研(yán)高品質消泡劑
不(bú)忘初心·隻為消泡 - 消泡劑技術服務熱(rè)線:134-3367-8080
 一對一溝通(tōng)消泡劑報價
一對一溝通(tōng)消泡劑報價




| 型號(hào): | DP-160 | 成分: | 有機(jī)矽 |
| 外觀: | 乳白色液體 | 添加量: | 0.01%~0.1% |
| PH值: | 6~8 | 水溶性: | 易(yì)分散 |
| 常規包裝: | 25/50/60/200/1000KG | 開稀: | 根據指導開稀1~20倍使用 |
1、消泡、抑泡力強,用量少,不影響(xiǎng)起泡體係的基本性質。
2、耐熱性好,化學性(xìng)穩定(dìng),通用性強、不燃、不爆。
3、性價比(bǐ)高,天(tiān)峰現(xiàn)貨直銷。
液體菌種消泡劑廣(guǎng)泛應用(yòng)於:菌種發酵、食用(yòng)菌發酵(jiào)、芽孢菌發酵、阿維菌素發酵、乳酸(suān)菌發酵等。
 某菌種發酵泡沫治(zhì)理案(àn)例 某菌種發酵泡沫治(zhì)理案(àn)例
|
 某(mǒu)食用菌(jun1)發酵泡沫治理案例 某(mǒu)食用菌(jun1)發酵泡沫治理案例
|
芽孢菌發酵泡沫治理案例
|








